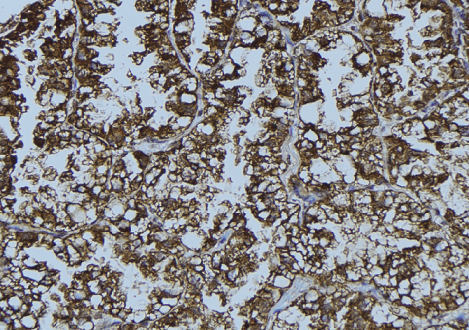
product-image-AAA325895_IHC15.jpg

Rabbit DDX58 Polyclonal Antibody | anti-DDX58 antibody
DDX58 Antibody
Phosphate buffered saline, pH 7.4, 150mM NaCl, 0.02% sodium azide and 50% glycerol.
WB (Western Blot)
(Western blot analysis of Mouse heart lysate, using DDX58 Antibody. The lane on the left is treated with the antigen-specific peptide.)
IHC (Immunohistochemistry)
(AAA325895 at 1/100 staining Mouse testis tissue by IHC-P. The sample was formaldehyde fixed and a heat mediated antigen retrieval step in citrate buffer was performed. The sample was then blocked and incubated with the antibody for 1.5 hours at 22 degree C. An HRP conjugated goat anti-rabbit antibody was used as the secondary.)
Function: Innate immune receptor which acts as a cytoplasmic sensor of viral nucleic acids and plays a major role in sensing viral infection and in the activation of a cascade of antiviral responses including the induction of type I interferons and proinflammatory cytokines. Its ligands include: 5'-triphosphorylated ssRNA and dsRNA and short dsRNA (< 1 kb in length). In addition to the 5'-triphosphate moiety, blunt-end base pairing at the 5'-end of the RNA is very essential. Overhangs at the non-triphosphorylated end of the dsRNA RNA have no major impact on its activity. A 3'overhang at the 5'triphosphate end decreases and any 5'overhang at the 5' triphosphate end abolishes its activity. Upon ligand binding it associates with mitochondria antiviral signaling protein (MAVS/IPS1) which activates the IKK-related kinases: TBK1 and IKBKE which phosphorylate interferon regulatory factors: IRF3 and IRF7 which in turn activate transcription of antiviral immunological genes, including interferons (IFNs); IFN-alpha and IFN-beta. Detects both positive and negative strand RNA viruses including members of the families Paramyxoviridae: Human respiratory syncytial virus and measles virus (MeV), Rhabdoviridae: vesicular stomatitis virus (VSV), Orthomyxoviridae: influenza A and B virus, Flaviviridae: Japanese encephalitis virus (JEV), hepatitis C virus (HCV), dengue virus (DENV) and west Nile virus (WNV). It also detects rotavirus and reovirus. Also involved in antiviral signaling in response to viruses containing a dsDNA genome such as Epstein-Barr virus (EBV). Detects dsRNA produced from non-self dsDNA by RNA polymerase III, such as Epstein-Barr virus-encoded RNAs (EBERs). May play important roles in granulocyte production and differentiation, bacterial phagocytosis and in the regulation of cell migration.
Subunit Structure: Monomer; maintained as a monomer in an autoinhibited state. Upon viral dsRNA binding and conformation shift, homomultimerizes and interacts (via tandem CARD domain) with MAVS/IPS1 promoting its filamentation. Interacts with DHX58/LGP2, IKBKE, TBK1 and TMEM173/STING. Interacts (via CARD domain) with TRIM25 (via SPRY domain). Interacts with RNF135. Interacts with CYLD. Interacts with NLRC5; blocks the interaction of MAVS/IPS1 to DDX58. Interacts with SRC. Interacts with DDX60. Interacts with isoform 2 of ZC3HAV1 (via zinc-fingers) in an RNA-dependent manner. Interacts (via tandem CARD domain) with SEC14L1; the interaction is direct and impairs the interaction of DDX58 with MAVS/IPS1. Interacts with VCP/p97; interaction is direct and leads to recruit RNF125 and subsequent ubiquitination and degradation (PubMed:26471729). Interacts with NOP53; may regulate DDX58 through USP15-mediated 'Lys-63'-linked deubiquitination (PubMed:27824081). Interacts with LRRC25 (PubMed:29288164).
Post-translational Modifications: Phosphorylated in resting cells and dephosphorylated in RNA virus-infected cells. Phosphorylation at Thr-770, Ser-854 and Ser-855 results in inhibition of its activity while dephosphorylation at these sites results in its activation. ISGylated. Conjugated to ubiquitin-like protein ISG15 upon IFN-beta stimulation. ISGylation negatively regulates its function in antiviral signaling response. Sumoylated, probably by MUL1; inhibiting its polyubiquitination. Ubiquitinated. Undergoes 'Lys-48'-and 'Lys-63'-linked ubiquitination. Lys-172 is the critical site for TRIM25-mediated ubiquitination, for MAVS/IPS1 binding and to induce anti-viral signal transduction (PubMed:17392790). Lys-154, Lys-164 and Lys-172 are critical sites for RNF135-mediated and TRIM4-mediated ubiquitination (PubMed:19017631, PubMed:19484123, PubMed:24755855). Deubiquitinated by CYLD, a protease that selectively cleaves 'Lys-63'-linked ubiquitin chains (PubMed:18636086). Also probably deubiquitinated by USP17L2/USP17 that cleaves 'Lys-48'-and 'Lys-63'-linked ubiquitin chains and positively regulates the receptor (PubMed:20368735). Ubiquitinated at Lys-181 by RNF125, leading to its degradation: ubiquitination takes place upon viral infection and is enhanced 'Lys-63'-linked ubiquitination of the CARD domains, which promote interaction with VCP/p97 and subsequent recruitment of RNF125 (PubMed:17460044, PubMed:26471729). Ubiquitinated at Lys-812 by CBL, leading to its degradation: ubiquitination takes place upon viral infection and involves 'Lys-48'-linked ubiquitination (By similarity).
Similarity: The RLR CTR domain controls homomultimerization and interaction with MAVS/IPS1. In the absence of viral infection, the protein is maintained as a monomer in an autoinhibited state with the CARD domains masked through intramolecular interactions mediated by the RLR CTR domain. Upon binding to viral RNA in the presence of ATP, the RLR CTR domain induces a conformational change exposing the CARD domain and promotes dimerization and CARD interactions with the adapter protein MAVS/IPS1 leading to the induction of downstream signaling.The helicase domain is responsible for dsRNA recognition.The 2 CARD domains are responsible for interaction with and signaling through MAVS/IPS1 and for association with the actin cytoskeleton.The second CARD domain is the primary site for 'Lys-63'-linked ubiquitination. Belongs to the helicase family. RLR subfamily.
NCBI and Uniprot Product Information
Predicted: 107 kDa
Customer Reviews
Loading reviews...
Share Your Experience
Similar Products
Product Notes
The DDX58 ddx58 (Catalog #AAA325895) is an Antibody produced from Rabbit and is intended for research purposes only. The product is available for immediate purchase. The DDX58 Antibody reacts with Human, Mouse, Rat and may cross-react with other species as described in the data sheet. AAA Biotech's DDX58 can be used in a range of immunoassay formats including, but not limited to, ELISA, IHC (Immunohistochemistry), WB (Western Blot). Researchers should empirically determine the suitability of the DDX58 ddx58 for an application not listed in the data sheet. Researchers commonly develop new applications and it is an integral, important part of the investigative research process. It is sometimes possible for the material contained within the vial of "DDX58, Polyclonal Antibody" to become dispersed throughout the inside of the vial, particularly around the seal of said vial, during shipment and storage. We always suggest centrifuging these vials to consolidate all of the liquid away from the lid and to the bottom of the vial prior to opening. Please be advised that certain products may require dry ice for shipping and that, if this is the case, an additional dry ice fee may also be required.Precautions
All products in the AAA Biotech catalog are strictly for research-use only, and are absolutely not suitable for use in any sort of medical, therapeutic, prophylactic, in-vivo, or diagnostic capacity. By purchasing a product from AAA Biotech, you are explicitly certifying that said products will be properly tested and used in line with industry standard. AAA Biotech and its authorized distribution partners reserve the right to refuse to fulfill any order if we have any indication that a purchaser may be intending to use a product outside of our accepted criteria.Disclaimer
Though we do strive to guarantee the information represented in this datasheet, AAA Biotech cannot be held responsible for any oversights or imprecisions. AAA Biotech reserves the right to adjust any aspect of this datasheet at any time and without notice. It is the responsibility of the customer to inform AAA Biotech of any product performance issues observed or experienced within 30 days of receipt of said product. To see additional details on this or any of our other policies, please see our Terms & Conditions page.Item has been added to Shopping Cart
If you are ready to order, navigate to Shopping Cart and get ready to checkout.